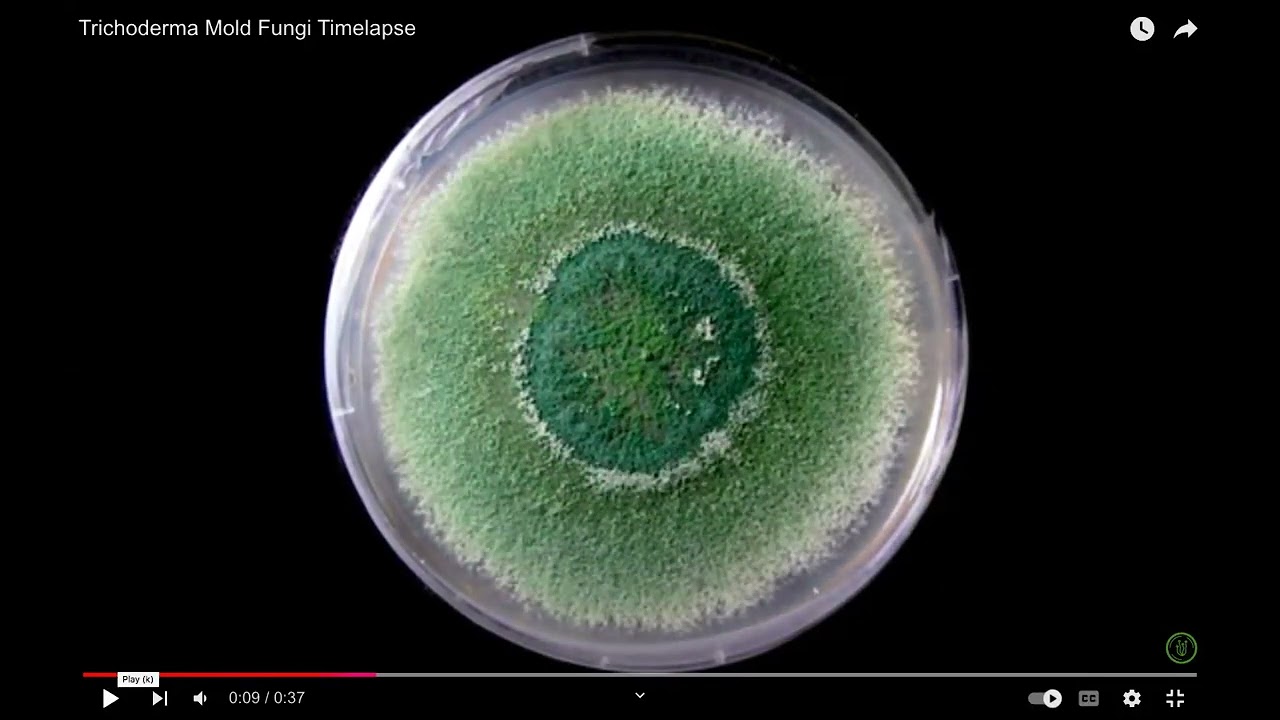
Growth Nature of Trichoderma Fungi ( Review Video of EverymanBio)

Growth Nature of Trichoderma Fungi ( Review Video of EverymanBio)
Автор: Than Than Sein
Загружено: 2024-12-02
Просмотров: 1059
My objective for this review video is to have a wonderful experience with fungal growth. It was circular and sporulation with a green color. EverymanBio took the photo once 20 minutes within 5 days. Thank you so much for your great effort.
Доступные форматы для скачивания:
Скачать видео mp4
-
Информация по загрузке:



















